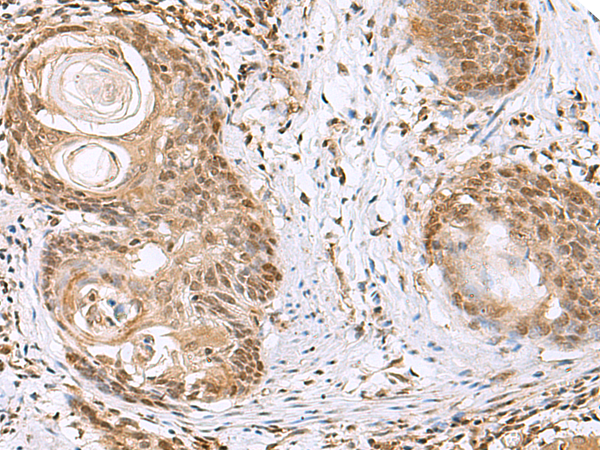

|
Background: |
Zinc phosphodiesterase, which displays some tRNA 3'-processing endonuclease activity. Probably involved in tRNA maturation, by removing a 3'-trailer from precursor tRNA. |
|
Applications: |
ELISA, WB, IHC |
|
Name of antibody: |
ELAC1 |
|
Immunogen: |
Fusion protein of human ELAC1 |
|
Full name: |
elaC ribonuclease Z 1 |
|
Synonyms: |
D29 |
|
SwissProt: |
Q9H777 |
|
ELISA Recommended dilution: |
5000-10000 |
|
IHC positive control: |
Human ovarian cancer |
|
IHC Recommend dilution: |
50-300 |
|
WB Predicted band size: |
40 kDa |
|
WB Positive control: |
293T, PC3, A549 and HepG2 cell lysates |
|
WB Recommended dilution: |
1000-5000 |
購物車
幫助
021-54845833/15800441009
